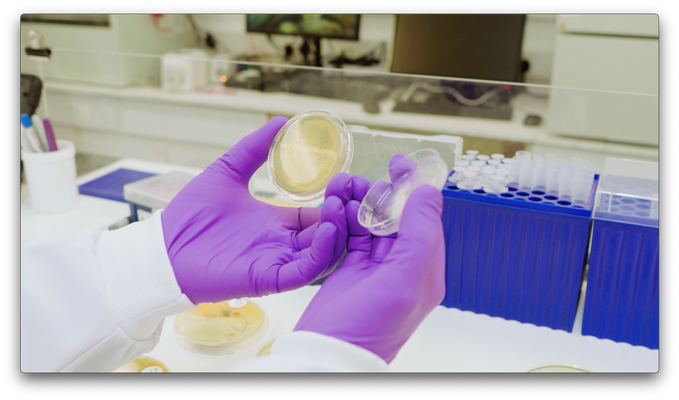

We partnered with Highlands and Islands Enterprise to produce two films showcasing the growth and potential of the life sciences sector in the Highlands of Scotland.
Combining footage from over 20 businesses with newly captured interviews, the films highlight the diversity of organisations, people and environments shaping the sector. From human and animal health to environmental innovation, the project brings together a wide range of voices to tell a collective story of collaboration, ambition and regional strength.
The films were designed for both local and international audiences, with one focusing on the people and community behind the sector, and the other positioning the Highlands as a compelling destination for inward investment.
2025
Inverness
Director: Jimmy Hyland
Producer / Assistant Producer: Elena Melton
Editor: Bob Zane